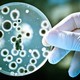
Antibiotic resistant bacteria mcdonalds

-
In the 1920s and 1930s, before antibiotics were developed, bacterial infections were basically a death sentence. Someone could get a small cut on they hand, have it get infected, and end up dead because there was nothing doctors could do at that point in time. The need for a solution to these bacterial infections was highlighted in this time.
-
The first antibiotic, penicillin, was invented in 1928 by Sir Alexander Fleming. It was accidentally discovered after Alexander had returned to his dirty lab from being on vacation and found Penicillium notatum mold growing on his petri dishes. He examined the mold under a microscope and found that it was limiting the growth of the colonies of bacteria he was trying to grow on the petri dishes. Thus, penicillin was discovered.
-
During WWII, Penicillin was widely used to treat soldiers with bacterial infections in battle. Many soldiers would not have made it home to see their families if it weren't for the "miracle" drug. However, this was not good for bacteria resistance because soldiers began abusing the drug and using it when they didn't really need it. Shortly after the war, penicillin resistance became a substantial problem in the U.S.
-
In the mid 1940s, Penicillin was starting to become mass produced. It was thought of as a miracle drug and started a whole new revolution of medical discovery. Because it was so new and so popular, it was prescribed for almost anything and everything, especially for soldiers in battle. Video
-
In the 1940s, the main treatment for S. aureus infections (Staph infections or Staphylococcus aureus) was the "miracle drug" penicillin. However, because of the misuse and overuse of drugs, by the late 1940s and 1950s, S. aureus started to become resistant to penicillin. A new drug called Methicillin was then discovered to treat the growing problem of penicillin resistant S. aureus. Methicillin became the most common treatment for staph infections.
-
The antibiotic colistin was discovered in the year 1949. This was an important discovery because in today's world, colistin is used as a last resort drug to treat bacterial diseases and infections that are resistant to all other antibiotics. After the discovery of colistin, it's usage was restricted to only being used for lung infections in cystic fibrosis patients with multi-drug resistant (MDR) bacterial infections.
-
In October of 1951, a woman named Henrietta Lacks died of cervical cancer in Johns Hopkins Hospital. Without her family's consent, cells were taken from her body and used for research. Her cells were the first human tumor cells to be grown outside of the human body. HeLa cells, revolutionized the world of medicine and helped in the development of new vaccines, in vitro fertilization techniques, and genetics research. Video
-
In the United States of American in 1968, first case of methicillin-resistant S. aureus (staph infection) was identified. This infection later became known as MRSA. The discovery of MRSA caused growing concern because it proved how much a bacterial infection can evolve and gain resistance against drugs. The first case (not in U.S.) of MRSA was found only 2 years after the clinical use of methicillin began. Video
-
In the late 1960s through the 1980s, the pharmaceutical industry created many new antibiotics. They created these antibiotics in a hope to combat the growing antibiotic problem. Unfortunately, because of this large burst of new antibiotics, shortly after there was a huge decline in new drug discovery, only putting the U.S. back in a scary place of bacterial resistance.
-
In 1972, the antibiotic Vancomycin was starting to be introduced into the medical field. It was an important antibiotic discovery because the drug could be used for the treatment of methicillin resistance (like MRSA). The drug began to give hope for antibiotic resistance and it was believed that it was almost impossible for bacteria to become resistant to vancomycin.
-
A frightening new discovery of the mcr-1 gene in E. coli bacteria was found in an American patient. The E. coli bacteria carrying the MCR-1 gene was found in a urine sample from a woman from Pennsylvania. To raise concerns even farther, the woman had no recent travels outside of the U.S. The mcr-1 gene is such a concern because it makes bacteria resistant to antibiotic colistin, a last resort antibiotic. Video
Plan projects on a visual timeline
Map milestones, phases, deadlines, and key events in one place so the sequence is easier to see and share. Timetoast is a timeline maker for work, school, research, and stories.